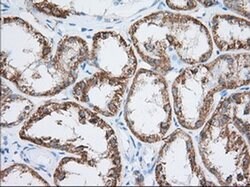

Promotional price valid on web orders only. Your contract pricing may differ. Interested in signing up for a dedicated account number?
Learn More
Learn More
Invitrogen™ HIBCH Monoclonal Antibody (OTI3H5)


Mouse Monoclonal Antibody
Supplier: Invitrogen™ MA525150
Description
HIBCH Monoclonal Antibody for Western Blot, IHC (P), Flow
Beta-hydroxyisobutyryl-CoA hydrolase (EC 3.1.2.4) is responsible for the specific hydrolysis of HIBYL-CoA, a valine catabolite, as well as the hydrolysis of beta-hydroxypropionyl-CoA, an intermediate in a minor pathway of propionate metabolism.
Specifications
| HIBCH | |
| Monoclonal | |
| 0.9 mg/mL | |
| PBS with 1% BSA, 50% glycerol and 0.02% sodium azide; pH 7.3 | |
| Q6NVY1 | |
| HIBCH | |
| Full length human recombinant protein of HIBCH produced in HEK293T cell. | |
| 100 μL | |
| Primary | |
| Human, Canine | |
| Antibody | |
| IgG2a |
| Flow Cytometry, Immunohistochemistry (Paraffin), Western Blot | |
| OTI3H5 | |
| Unconjugated | |
| HIBCH | |
| 2610509I15Rik; 3-hydroxyisobutyryl-CoA hydrolase; 3-hydroxyisobutyryl-CoA hydrolase, mitochondrial; 3-hydroxyisobutyryl-coenzyme A hydrolase; AI648812; Hibch; HIB-CoA hydrolase; HIBYLCOAH; HIBYL-CoA-H; testicular tissue protein Li 86 | |
| Mouse | |
| Affinity Chromatography | |
| RUO | |
| 26275, 607040 | |
| -20°C, Avoid Freeze/Thaw Cycles | |
| Liquid |
Product Content Correction
Your input is important to us. Please complete this form to provide feedback related to the content on this product.
Product Title
Spot an opportunity for improvement?Share a Content Correction